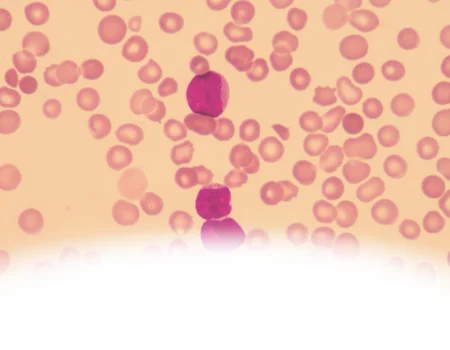
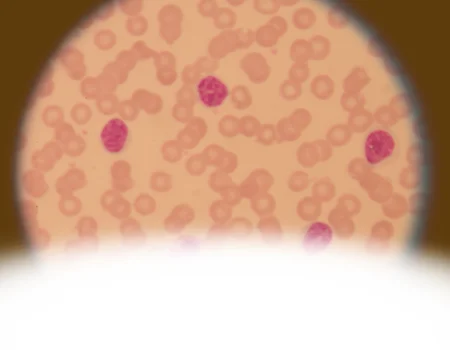

O único curso com mentoria 24hrs
Desenvolva sua capacidade de análise e liberação de laudos em 8 aulas práticas
curso de morfologia de leucemias e linfomas
Aprenda a identificar com segurança células anormais em 13 tipos de linfomas, leucemias agudas e crônicas através de casos reais, com suporte especializado em cada análise

Curso Prático com Mentoria 24h
Em um cenário onde cada laudo pode impactar diretamente a conduta terapêutica, sua capacidade de identificar com precisão células anormais faz toda a diferença. Mas a realidade é que mesmo profissionais experientes enfrentam desafios diante de casos complexos de leucemias e linfomas.
O que aconteceria se você pudesse ter ao seu lado, durante 8 aulas intensivas, um especialista em morfologia hematológica, analisando casos reais e recebendo feedback instantâneo sobre cada identificação?
Você já se perguntou...
Como ter mais segurança na diferenciação morfológica entre LMA e LLA em casos desafiadores?
Como garantir que sua identificação de células anormais está realmente precisa?
O que fazer quando se depara com morfologias atípicas que não se encaixam nos padrões usuais?
Como lidar com a responsabilidade de liberar laudos que impactam diretamente a conduta terapêutica?"
Apresentamos o MLL - Imersão em Morfologia das Leucemias e Linfomas
Uma experiência de aprendizado única que combina:

8 encontros ao vivo de prática intensiva com casos reais

25 laudos e lâminas criteriosamente selecionados para cobrir os casos mais desafiadores

Treinamento específico em identificação de todos os tipos de células anormais

Metodologia prática desenvolvida com base em milhares de casos reais
O Que Você Vai Aprender
26 aulas objetivas e práticas divididas em módulos essenciais:
Módulo 1: Leucemias Agudas
- Identifique com precisão LMA, LLA e LPA
- Domine a caracterização morfológica dos blastos
- Desenvolva olhar crítico para casos atípicos

Módulo 2: Linfomas em Sangue Periférico
- Reconheça os 13 principais tipos de linfomas
- Diferencie com segurança células reativas de neoplásicas
- Aprenda a documentar achados significativos
Módulo 3: Leucemias Crônicas
- Identifique alterações características da LMC
- Reconheça padrões de mielofibrose e trombocitemia essencial
- Analise casos de leucemia de eosinófilos

Módulo 4: Alterações Mieloproliferativas
- Caracterize neutrófilos hipogranulares
- Identifique alterações em megacariócitos
- Avalie alterações displásicas

Módulo 5: Células Linfoides Anormais
- Diferencie linfócitos atípicos de células neoplásicas
- Identifique células de Sézary
- Reconheça tricoleucócitos

Módulo 6: Plasmócitos e Alterações Associadas
- Avalie morfologia de plasmócitos no mieloma múltiplo
- Identifique alterações características
- Analise casos complexos

Módulo 7: Análise Integrada
- Desenvolva metodologia sistemática de análise
- Pratique com casos desafiadores
- Aprenda a documentar achados críticos

Módulo 8: Consolidação e Casos Especiais
- Analise casos raros e complexos
- Pratique identificação de células difíceis
- Consolide metodologia de análise
GARANTIR SUA VAGA AGORA
Aprenda com quem literalmente escreveu um livro sobre o assunto:
- Autor do 'Atlas do Sangue Periférico e Doenças Hematológicas
- Mais de 20 anos formando especialistas em hematologia
- Doutor pela UFPE e Mestre pela UNIFESP
- Consultor dos principais laboratórios do país
- Desenvolvedor de metodologias exclusivas de ensino em morfologia"
GARANTIR SUA VAGA AGORA
Garantia
Garantia de 7 dias ou seu dinheiro de volta Se após a primeira semana de curso você não estiver completamente satisfeito com o conteúdo e a metodologia, devolvemos 100% do seu investimento, sem questionamentos.

Perguntas Frequentes
Sim! Você recebe certificado de 40 horas reconhecido por instituições de ensino e empregadores.
Absolutamente! O curso foi estruturado para criar uma base sólida, independente do seu nível atual.
Todas as aulas são gravadas e disponibilizadas em até 24h, e você ainda pode tirar dúvidas diretamente com o professor pelo WhatsApp.
SEJA REFERÊNCIA EM MORFOLOGIA HEMATOLÓGICA
MLL 2025 © Todos os direitos reservados
